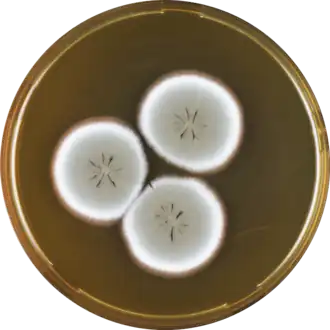

Аспергилл желтоножковый
| Аспергилл желтоножковый | ||||||||||
|---|---|---|---|---|---|---|---|---|---|---|
| ||||||||||
| Научная классификация | ||||||||||
|
Домен: Царство: Подцарство: Отдел: Подотдел: Класс: Подкласс: Eurotiomycetidae Порядок: Семейство: Aspergillaceae Род: Секция: Flavipedes Вид: Аспергилл желтоножковый |
||||||||||
| Международное научное название | ||||||||||
| Aspergillus flavipes (Bainier & Sartory) Thom & Church, 1926 | ||||||||||
| ||||||||||
Асперги́лл желтоно́жковый[1] (лат. Aspergíllus flávipes) — вид несовершенных аскомицетовых грибов, относящийся к роду Аспергилл (Aspergillus).
Редкий вид, известный всего по двум штаммам.
Описание
Колонии на агаре Чапека с дрожжевым экстрактом (CYA) 4—5,5 см в диаметре на 14-е сутки, шерстистые, белые до желтовато-белых. Реверс колоний жёлто-оранжевый различной интенсивности.
На агаре с солодовым экстрактом (MEA) колонии 3,5—6 см в диаметре на 14-е сутки, шерстистые, желтовато-белые до жёлто-коричневых. Реверс оранжево-жёлтый до жёлто-коричневого.
На агаре Чапека колонии 3,5—5 см в диаметре на 14-е сутки, шерстистые, белые до бледно-жёлто-коричневых, с бледно-желтоватым реверсом.
При 37 °C колонии на CYA 17—19 мм в диаметре на 7-е сутки, при 40 °C на CYA рост отсутствует.
Конидиеносные головки двухъярусные, редко одноярусные, ножки иногда до 1 мм и более длиной, часто пигментированные, гладкостенные, с лопатчатым до грушевидного апикальным вздутием до 12—16 × 7—11 мкм. Метулы покрывающие до двух третей вздутия, 3—7 мкм длиной. Фиалиды 4,5—6,5 мкм длиной. Конидии в основном шаровидные, гладкостенные, 2—3 мкм в диаметре. Покровных клеток не образует[2].
Отличия от близких видов
Определяется по апикальным вздутиям конидиеносцев с усечённым основанием (лопатчатой формы) и неспособности образовывать покровные клетки (клетки Хюлле).
Экология и распространение
Вид известен всего по двум штаммам, один из которых был выделен с отмершего жёсткокрылого в Уругвае. Происхождение второго известного штамма, к которому относится эпитип вида, не установлено.
Широкое распространение вида, указывающееся в литературе, по-видимому, относится к близкому виду Aspergillus frequens Hubka et al.[2]
Таксономия
Fennellia flavipes B.J.Wiley & E.G.Simmons, изначально описанный как совершенная стадия (телеоморфа) Aspergillus flavipes, на основании молекулярно-филогенетических данных с 2010-х годов синонимизирован с близким видом — Aspergillus neoflavipes Hubka et al. Aspergillus flavipes известной соверщенной стадии не имеет[2].
Номенклатурным типом (лектотипом) Aspergillus flavipes является иллюстрация Sterigmatocystis flavipes Бенье и Сартори. Эпитипом в 2015 году был выбран гербарный образец Herb. IMI 171885, полученный из культуры NRRL 302. Происхождение этой культуры не установлено.
Aspergillus flavipes (Bainier & Sartory) Thom & Church, The Aspergilli 155 (1926). — Sterigmatocystis flavipes Bainier & Sartory, Bull. Soc. Mycol. France 27: 90 (1911).
Синонимы
- Aspergillus archiflavipes Blochwitz, 1934
- Sterigmatocystis flavipes Bainier & Sartory, 1911[2]
Примечания
Литература
- Hubka V., Nováková A., Kolařík M. et al. Revision of Aspergillus section Flavipedes: seven new species and proposal of section Jani sect. nov. — Mycologia. — 2015. — Vol. 107, no. 1. — P. 169—208. — doi:10.3852/14-059.
- Pitt J. I., Hocking A. D. Fungi and Food Spoilage. — Springer, 2009. — P. 303—305. — ISBN 978-0-387-92206-5. — doi:10.1007/978-0-387-92207-2.
- Пидопличко Н. М. Грибы-паразиты культурных растений. — Киев: Наукова думка, 1977. — Т. 2. — С. 51.